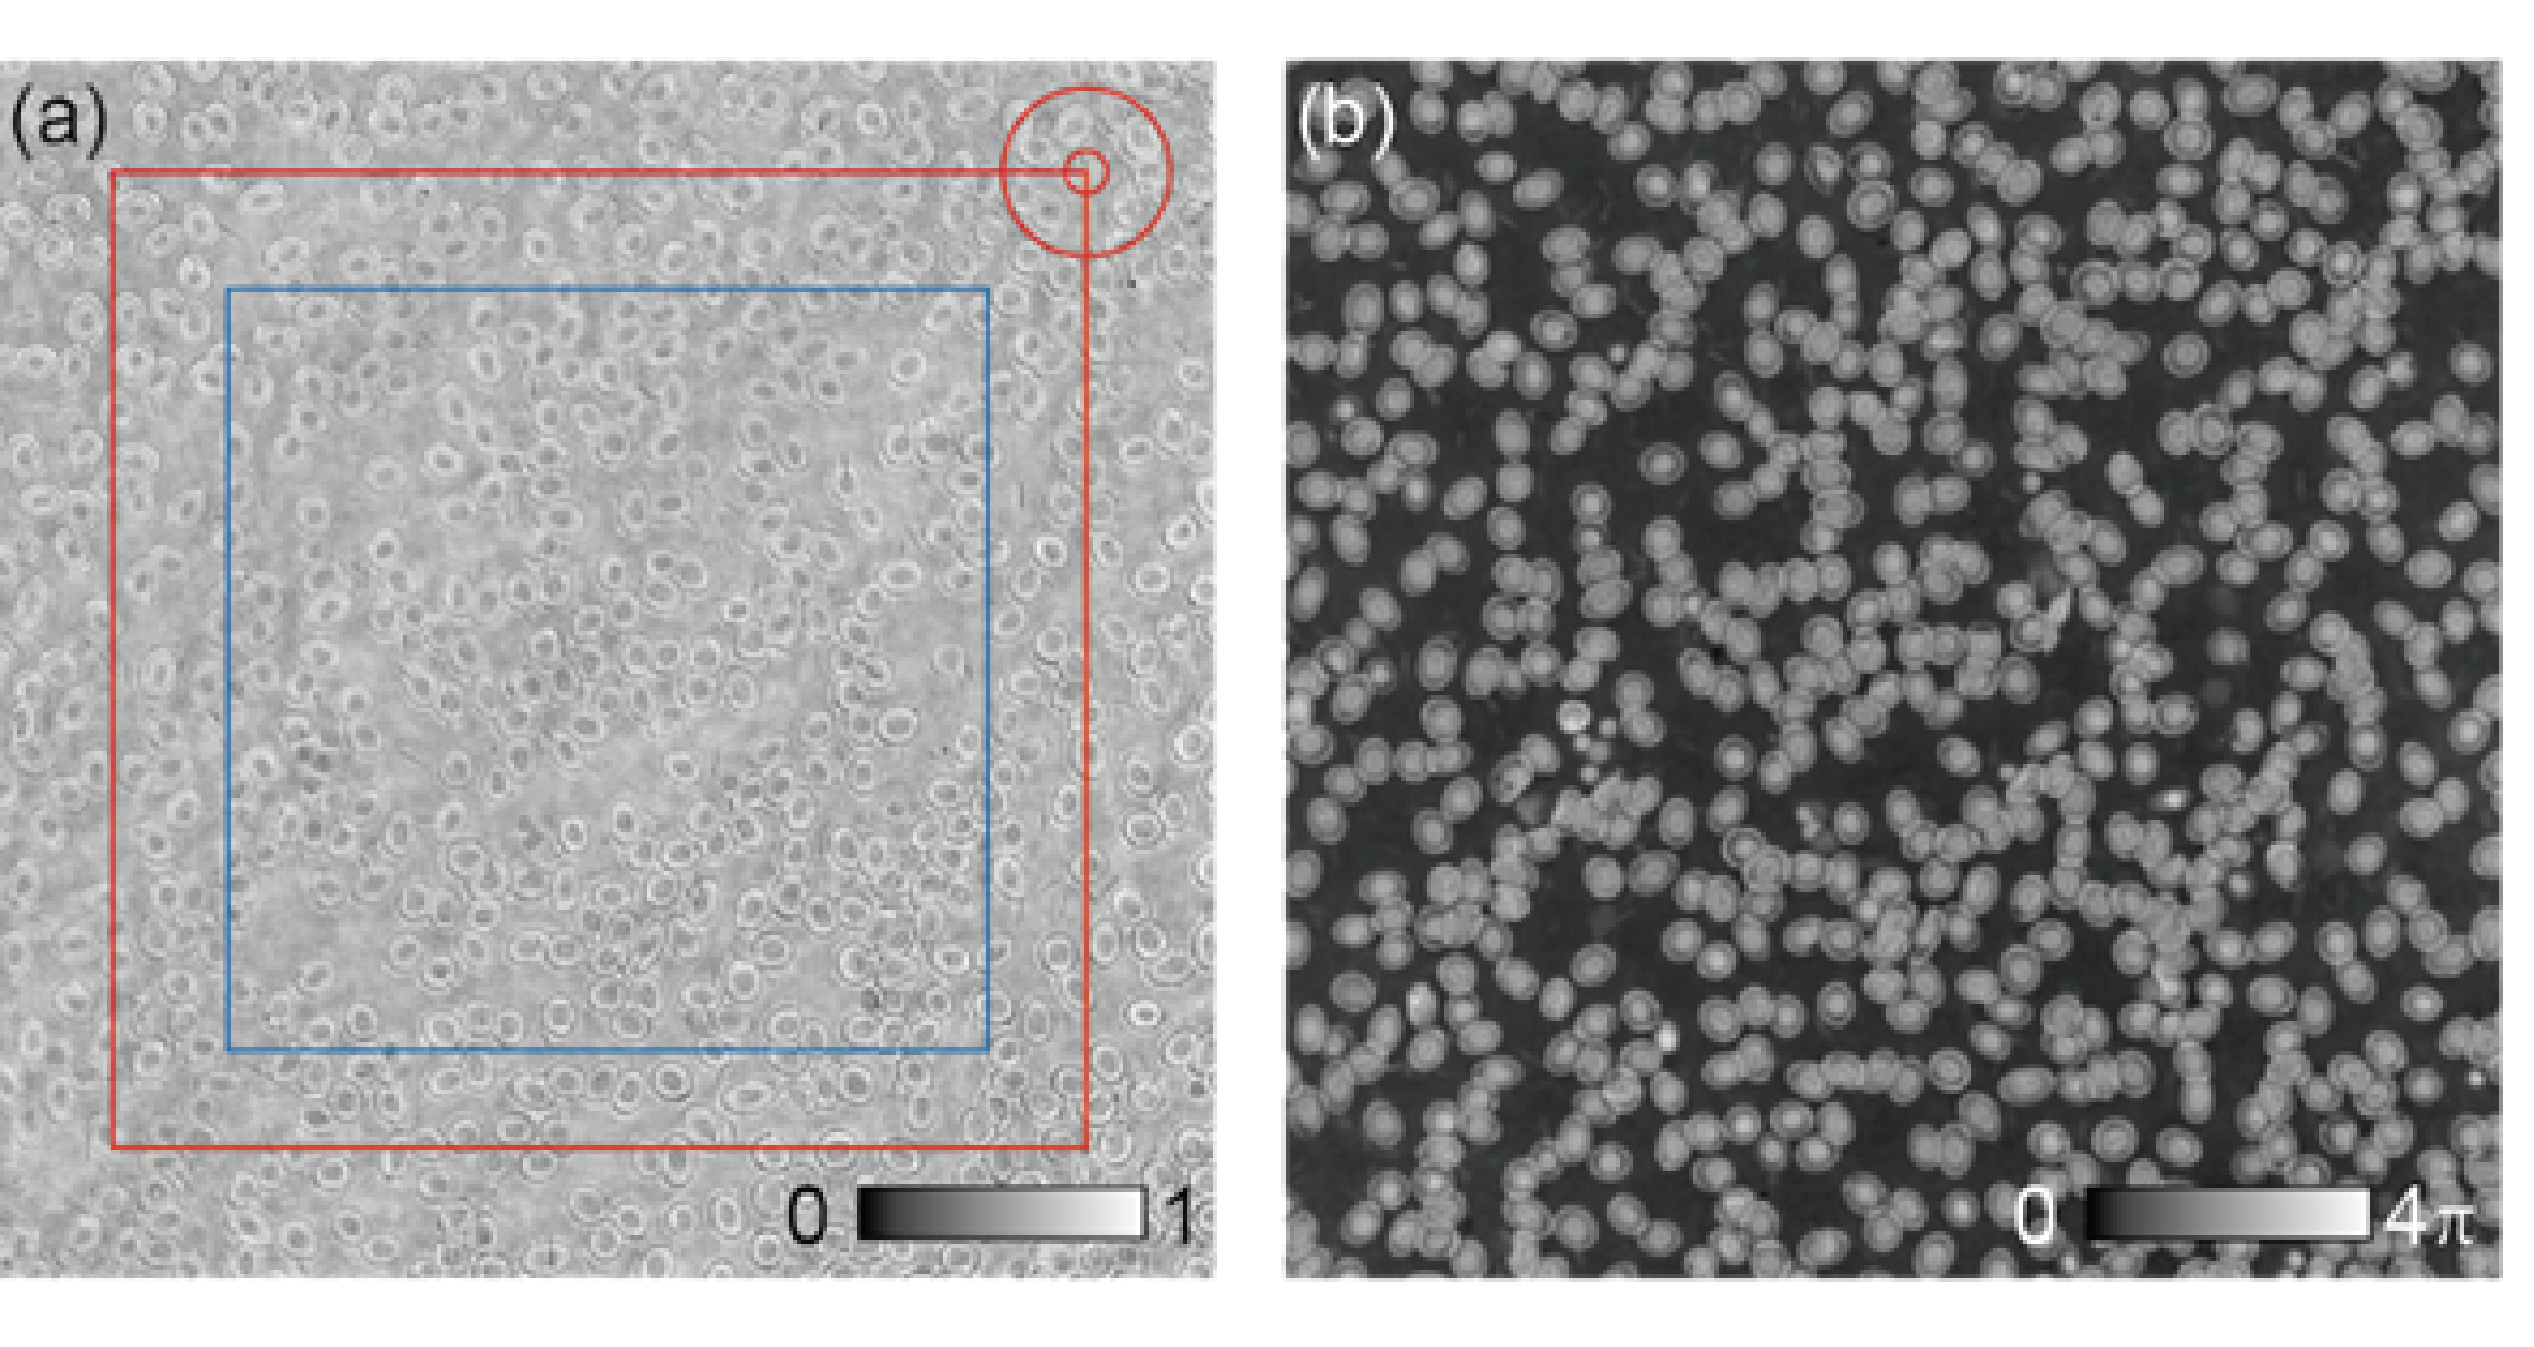
Refer to caption

Set projection algorithms for blind ptychographic phase retrieval
Abstract
Set projection algorithms are a class of algorithms used in ptychography to help improve the quality of the reconstructed images. In this paper, existing and new projection algorithms for ptychography are described and compared.
I Introduction
Set projection algorithms play a critical role in the reconstruction process of ptychography, and their performance greatly affects the accuracy and quality of the final images. Different set projection algorithms combine and iterate between the projections onto constraint sets in different ways, generally, these projections can be defined by a relaxed projection notation , where indicates the constraint set and indicates the relaxation. When , represents the standard projection of onto . In terms of the standard projection, relaxed projection can be written as , where is the identity operator. When , it moves only a fraction of the distance toward , which is under-relaxed projection, another way is over-relaxed projection, where and moves beyond . There is a special case called reflection about a constraint set, where , , which moves twice as far as in the same direction. A geometric example of three non-convex constraint sets is illustrated in Fig. 1. The arrows from in Fig.1 show several different projections with different degrees of relaxation.

To find the intersection of constraint sets , a single projection is clearly not enough, the Sequential Projections (SP) algorithm is the most intuitive way to combine these projection operations into an algorithm to solve this problem. As shown in Fig.2, given an initial start point , the algorithm projects onto one of the constraints , takes the result of this projection and projects it onto a second constraint , finally, projects onto constraint , the result of this sequence of projections is the point in Fig.2. Then repeats, the next iteration starts from point , the order of projections can either be fixed or with the order shuffled at random between iterations, moreover, the relaxation of each projection also can be changed during sequential projections for better performance.

However, because the Sequential Projections algorithm cycles through the constraint sets sequentially, it can become entrenched in periodic oscillations rather than reaching a settled point of convergence. This is especially true where the underlying data are noisy, so that the sets may not all intersect at a single solution point. Therefore, product space is used in many set projection algorithms to treat constraint sets collectively rather than sequentially to avoid this problem. The idea is that the project onto each of the constraint sets in parallel (the divide step), then these projections are averaged in some way to reach a single consensus solution (the concur step), the entire process is called ”divide and concur”[1]. The schematic diagram is shown in Fig.3

The product space in this instance consists of three copies of the 2D plane, each holding one of the circle constraints. Each 2D plane also has its own estimate of the solution, so that has three components: . The divide and concur approach begins with the divide step, shown in Fig.3(a), calculates the individual projection onto different sets. These parallel projections can be considered as a standard single ’divide’ projection in the product space, giving three new points . The next step is ”concur”, which averages the individual projections from the divide step. This averaging operation can also be expressed as a standard concur projection in the product space: . Therefore, the divide and concur (DC) algorithm, alternates between the divide and concur projections, the next iteration will be . By changing the relaxation of each projection, the DC approach can also be generalised as the equation below.
Where , and are relaxation parameters.
With appropriate choice of , and , this general formula can implement most major set projection algorithms. We investigate an overview of the main set projection algorithms used in ptychography, such as Divide and concur (DC), Average reflections (AR), Douglas Rachford (DR), Solvent flip (SF), Relaxed averaged alternating reflections (RAAR), Reflect reflect relax(RRR) and Tλ algorithm[1][2][3][4][5][6][7][8][9][10].
Fig.4. is a general flow diagram of the ‘abc’ ptychographic method, the computation starts with an initial guess of probe and object, then forms exit waves for all of the scan positions, do the projections, and finally updates probe and object.

A simulation on blood cells shows the different performance of these set projection algorithms, the object is shown in Fig. 5. and two different size of probes are shown in Fig.6.

The simulation results are shown in Fig.7. and Fig.8., which are the error metrics for different set projection algorithms.


II Conclusion
In conclusion, based on the generalised ’abc’ projection model, several different ptychographic projection methods are implemented and compared by adjusting the values of relaxation parameters ’abc’. In our simulation tests, Tλ algorithm is slightly better than Relaxed averaged alternating reflections (RAAR), and both of them have significantly better performance than other methods.
References
- [1] S. Gravel and V. Elser, “Divide and concur: A general approach to constraint satisfaction,” Phys. Rev. E, vol. 78, p. 036706, Sep 2008. [Online]. Available: https://link.aps.org/doi/10.1103/PhysRevE.78.036706
- [2] A. M. Maiden and J. M. Rodenburg, “An improved ptychographical phase retrieval algorithm for diffractive imaging,” Ultramicroscopy, vol. 109, no. 10, pp. 1256–1262, 2009.
- [3] V. Elser, I. Rankenburg, and P. Thibault, “Searching with iterated maps,” Proceedings of the National Academy of Sciences, vol. 104, no. 2, pp. 418–423, 2007.
- [4] S. Marchesini, “Invited article: A unified evaluation of iterative projection algorithms for phase retrieval,” Review of scientific instruments, vol. 78, no. 1, p. 011301, 2007.
- [5] N. H. Thao, “A convergent relaxation of the douglas–rachford algorithm,” Computational Optimization and Applications, vol. 70, no. 3, pp. 841–863, 2018.
- [6] V. Elser, “The complexity of bit retrieval,” IEEE Transactions on Information Theory, vol. 64, no. 1, pp. 412–428, 2018.
- [7] M. N. Dao and H. M. Phan, “Linear convergence of the generalized douglas–rachford algorithm for feasibility problems,” Journal of Global Optimization, vol. 72, pp. 443–474, 2018.
- [8] D. R. Luke, “Relaxed averaged alternating reflections for diffraction imaging,” Inverse problems, vol. 21, no. 1, p. 37, 2004.
- [9] P. Thibault, M. Dierolf, A. Menzel, O. Bunk, C. David, and F. Pfeiffer, “High-resolution scanning x-ray diffraction microscopy,” Science, vol. 321, no. 5887, pp. 379–382, 2008.
- [10] J. Abrahams and A. Leslie, “Methods used in the structure determination of bovine mitochondrial f1 atpase,” Acta Crystallographica Section D: Biological Crystallography, vol. 52, no. 1, pp. 30–42, 1996.